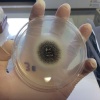

8 ч. назад
16
Лидером по оригинальным топонимам стала Воронежская область — здесь нашли 22 населённых пункта с необычными названиями, среди них Ендовище, Хреновище и Плясово-Китаево.
Курганская область заняла второе место (14 названий) — Духовка, Кокуй, Камчатка, Крепость. В Удмуртии есть деревни Двигатель и Мальчиково, в Алтае — Киска и Кукуя, в Краснодарском крае — Весёлая жизнь и Батарейка, в Подмосковье — Поцелуево и Свиноедово.
Эксперты отмечают: необычные названия часто связаны с историей мест, и, как говорят специалисты, «лучше смешное, чем безликое». Источник: ЧП РОССИЯ
Источник: ЧП РОССИЯ
Еще новости:
Сначала девушка думала, что это ОРВИ, затем бронхит. Но кашель не проходит уже 2 месяца.Оксане поставили диагноз — аллергический аспергиллез, осложненный кандидозом дыхательных путей. Болезнь вызывают опасные грибки. Сейчас кашель, по словам девушки, продолжается, появилась боль ... Читать далее >>
Парочки покупают туры в Таиланд, Турцию и Индонезию, чтобы отдыхать и одновременно снимать видео 18+ на пляжах. Затем контент выкладывают на порноплощадки, зарабатывая до 2 млн рублей в месяцОднако за производство порно в этих странах предусмотрена уголовная ответственность. Кроме того, за... Читать далее >>
Вермуты Martini Bianco и Martini Fiero будут делать на винодельнях в Дагестане. Производство планируется запустить с весны 2026 года.Всего планируется выпускать около 10 миллионов литров спиртного для внутреннего рынка. Это станет вторым крупным предприятием бренда за предела... Читать далее >>
Лидером по оригинальным топонимам стала Воронежская область — здесь нашли 22 населённых пункта с необычными названиями, среди них Ендовище, Хреновище и Плясово-Китаево.Курганская область заняла второе место (14 названий) — Духовка, Кокуй, Камчатка, Крепость. В Удмуртии есть деревни Двигате... Читать далее >>
С января по сентябрь этого года каждый житель области выпил 9,65 литров чистого спирта вместо 7,7. Это следует из официальной статистики. При этом в соседних регионах, где ограничений нет, потребление алкоголя с начала года снижается.С 1 марта алкоголь в Воло... Читать далее >>
Объект благоустроили только в этом году, однако радовал он местную детвору недолго: кто-то испоганил его, разлив повсюду масло. Источник: ЧП РОССИЯ... Читать далее >>
В документе также говорится о начале работы представительства Министерства труда и миграции Таджикистана в России.Главная цель этих представительств — укрепление сотрудничества между странами в вопросах миграции и борьбы с незаконным оборотом наркотиков.... Читать далее >>
На Северном Кавказе прихожанин заказал убийство двух пасторов за миллион рублей.В качестве задатка он перевел предполагаемому киллеру 30 тысяч рублей. Была организована инсценировка убийства одной из жертв. Об исполнении заказа сообщили инициатору преступления и в виде доказательств... Читать далее >>
Ростовского убийцу своих родственников задержали по горячим следам.Сейчас оперативники допрашивают Фёдора Миляева, чтобы узнать, что побудило его расправиться с родной сестрой прямо в её доме.Теперь преступника ждет арест, а затем ему предстоит провести много лет за решеткой.... Читать далее >>
На данный момент известно о десяти пострадавших. Из них пятеро госпитализированы, троих осмотрели на месте, двое скончались.Сейчас продолжаются поиски двух рабочих завода. Ист... Читать далее >>